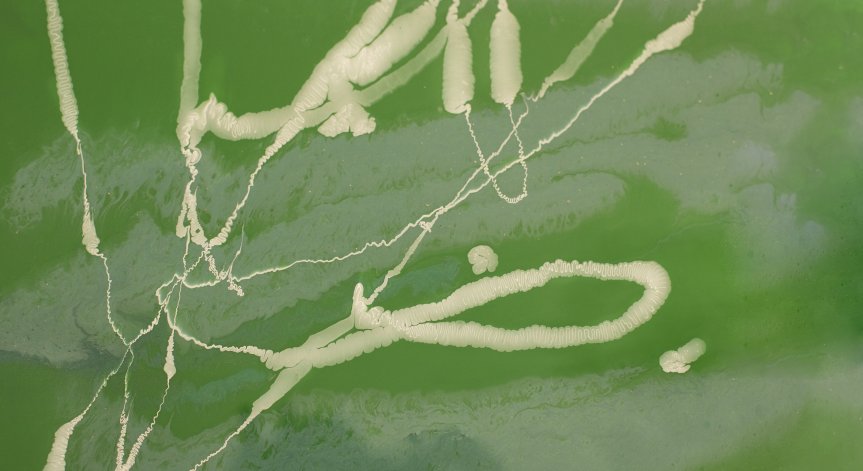
Лекарите открили паразита след рязко влошаване на състоянието.

В Китай лекари откриха жив паразит с дължина 18 сантиметра в мозъка на жител от провинция Хунан, съобщава Mothership.
През април 2024 г. здравето на мъжа започва да се влошава. Той се оплаквал от чужд предмет в очите си и мозаечни петна, плаващи в зрителното му поле. Прегледът от офталмолог не разкрива никакви аномалии.
Лекарите обаче забелязали аномалии в изображенията на магнитно-резонансна томография. Те биха могли да показват наличието на някакво чуждо тяло в мозъка. За да се провери това, се налагала операция. Мъжът обаче предпочел да се откаже от операция.
В края на юли 2025 г. състоянието му рязко се влошило: той започнал да припада, от устата му излизала пяна и изпадал в конвулсии. Операцията станала неизбежна, като от черепа му била извадена тения от рода Spirometra. След десет дни лечение и наблюдение мъжът бил изписан, информира БГНЕС.
Пациентът твърди, че преди много години е хванал змия, извадил жлъчния ѝ мехур и я глътнал сурова. Лекарите подозират, че именно тогава ларвите на паразита са попаднали в тялото му.
Снимка: Freepik

В кадър: Болезнена семейна драма разтърси Кан
В кадър: Болезнена семейна драма разтърси Кан  Още четири заявки за регистриране на марката "Бангаранга" зад гърба на Дара
Още четири заявки за регистриране на марката "Бангаранга" зад гърба на Дара  Ще стане ли "Бангаранга" дума на годината?
Ще стане ли "Бангаранга" дума на годината?  Как електромобилите променят световната икономика? Само по Bloomberg TV Bulgaria
Как електромобилите променят световната икономика? Само по Bloomberg TV Bulgaria 
 Инфекциозни обриви в детска възраст – морбили, 2
Инфекциозни обриви в детска възраст – морбили, 2  Първата Лятна академия за родители на "Пирогов" отново премина със засилен интерес
Първата Лятна академия за родители на "Пирогов" отново премина със засилен интерес  Предпочитанията към храна се оформят още в утробата на майката
Предпочитанията към храна се оформят още в утробата на майката  Персонализирано лечение и по-прецизна диагностика бяха във фокуса на XIII Международна среща на Клуб „Млад онколог“
Персонализирано лечение и по-прецизна диагностика бяха във фокуса на XIII Международна среща на Клуб „Млад онколог“ 
 дава под наем, Къща, 309 m2 София, Драгалевци, 4500 EUR
дава под наем, Къща, 309 m2 София, Драгалевци, 4500 EUR  продава, Многостаен апартамент, 45 m2 София, Суха Река, 99000 EUR
продава, Многостаен апартамент, 45 m2 София, Суха Река, 99000 EUR  продава, Тристаен апартамент, 72 m2 София, Овча Купел, 239000 EUR
продава, Тристаен апартамент, 72 m2 София, Овча Купел, 239000 EUR  продава, Тристаен апартамент, 50 m2 София, Витоша, 2500 EUR
продава, Тристаен апартамент, 50 m2 София, Витоша, 2500 EUR  дава под наем, Тристаен апартамент, 70 m2 София, Хиподрума, 650 EUR
дава под наем, Тристаен апартамент, 70 m2 София, Хиподрума, 650 EUR 
 Изследовател: САЩ са открили четири вида извънземни от катастрофирали НЛО
Изследовател: САЩ са открили четири вида извънземни от катастрофирали НЛО  Сигналът от „Вояджър 1“ вече пътува над 23 часа до Земята
Сигналът от „Вояджър 1“ вече пътува над 23 часа до Земята  Откриването на планети като Земята остава огромно предизвикателство за учените
Откриването на планети като Земята остава огромно предизвикателство за учените  Отложиха изстрелването на Starship V3: Кога ще гледаме тестовия полет?
Отложиха изстрелването на Starship V3: Кога ще гледаме тестовия полет? 
 От ПБ не разбират драмата с новия правилник на парламента
От ПБ не разбират драмата с новия правилник на парламента  КПС "Астери" Варна с 9 медала от Гран При в Бургас
КПС "Астери" Варна с 9 медала от Гран При в Бургас  „Прогресивна България“ ограничава правомощията на управителя на „Лукойл“
„Прогресивна България“ ограничава правомощията на управителя на „Лукойл“  Умно използване на финансови инструменти без излишен риск
Умно използване на финансови инструменти без излишен риск  Тома Биков: Ограничаването на парламентарния контрол е негативна тенденция
Тома Биков: Ограничаването на парламентарния контрол е негативна тенденция 
 Residential Investment Summit Bulgaria & CEE 2026: инвестиции, masterplanning и новата логика на жилищния сектор
Residential Investment Summit Bulgaria & CEE 2026: инвестиции, masterplanning и новата логика на жилищния сектор  Анализатор: Тръмп търси бърза сделка, а Китай играе стратегически за десетилетия
Анализатор: Тръмп търси бърза сделка, а Китай играе стратегически за десетилетия  Въглеродните емисии от сградния фонд в света нарастват с ускоряването на урбанизацията
Въглеродните емисии от сградния фонд в света нарастват с ускоряването на урбанизацията  Всяка четвърта доставка от електронната търговия у нас ще бъде насочена към автомати за пратки
Всяка четвърта доставка от електронната търговия у нас ще бъде насочена към автомати за пратки 







